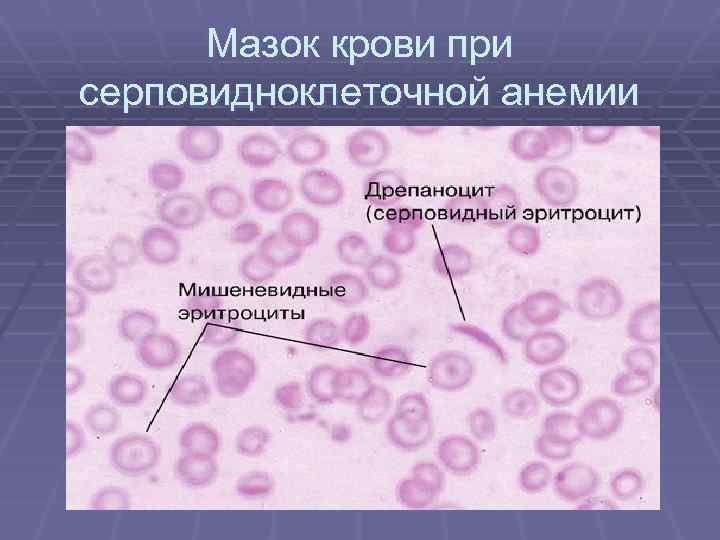
Мазок крови при серповидноклеточной анемии

гемолитические, гипопластические анемии.ppt
- Количество слайдов: 50
 Гемолитические анемии Кафедра госпитальной терапии ХМГМА доцент Н. Б. Булиева
Гемолитические анемии Кафедра госпитальной терапии ХМГМА доцент Н. Б. Булиева
 Гемолитические анемии - Это группа заболеваний, различающихся по этиологии , патогенезу, клинической картине и методам лечения, но объединенных одним основным признакомукорочением продолжительности жизни эритроцитов и усиленным их разрушением, что и приводит к уменьшению их в единице объема крови.
Гемолитические анемии - Это группа заболеваний, различающихся по этиологии , патогенезу, клинической картине и методам лечения, но объединенных одним основным признакомукорочением продолжительности жизни эритроцитов и усиленным их разрушением, что и приводит к уменьшению их в единице объема крови.
 Гемолитичекие анемии АНЕМИИ ОБУСЛОВЛЕННЫЕ УКОРОЧЕНИЕМ ДЛИТЕЛЬНОСТИ ЖИЗНИ ЭРИТРОЦИТОВ В СИЛУ ИХ ВНУТРЕННЕГО ДЕФЕКТА ИЛИ ВНЕШНИХ НЕБЛАГОПРИЯТНЫХ ФАКТОРОВ § ЭПИДЕМИОЛОГИЯ: у 0, 5 - 1, 0% населения (в Средиземноморье, Африке, на Кавказе - 5 50% населения).
Гемолитичекие анемии АНЕМИИ ОБУСЛОВЛЕННЫЕ УКОРОЧЕНИЕМ ДЛИТЕЛЬНОСТИ ЖИЗНИ ЭРИТРОЦИТОВ В СИЛУ ИХ ВНУТРЕННЕГО ДЕФЕКТА ИЛИ ВНЕШНИХ НЕБЛАГОПРИЯТНЫХ ФАКТОРОВ § ЭПИДЕМИОЛОГИЯ: у 0, 5 - 1, 0% населения (в Средиземноморье, Африке, на Кавказе - 5 50% населения).
 Виды гемолиза: § Внутриклеточный (секвестрационный)происходит в клетках ретикулоэндотелиальной системы, т. е. в селезенке, сопровождается увеличением свободного билирубина, уробилина в моче, кале и образованием конкрементов в жп и желчных протоках. § Внутрисосудистый гемолиз-гемоглобин проникает в плазму и выделяется с мочой либо в неизмененном виде, либо в виде гемосидерина.
Виды гемолиза: § Внутриклеточный (секвестрационный)происходит в клетках ретикулоэндотелиальной системы, т. е. в селезенке, сопровождается увеличением свободного билирубина, уробилина в моче, кале и образованием конкрементов в жп и желчных протоках. § Внутрисосудистый гемолиз-гемоглобин проникает в плазму и выделяется с мочой либо в неизмененном виде, либо в виде гемосидерина.
 Классификация ГА I. ВРОЖДЕННЫЕ Ø ЭРИТЦИТОПАТИИ =мембранопатии Ø Ø (МИКРОСФЕРОЦИТОЗ-б-нь Минковского-Шоффара; СФЕРОЦИТОЗ; ОВАЛОЦИТОЗ; СТОМАТОЦИТОЗ) ГЕМОГЛОБИНОПАТИИ (ТАЛАССЕМИЯ, СЕРПОВИДНОКЛЕТОЧНАЯ АНЕМИЯ) ФЕРМЕНТОПАТИИ (ДЕФИЦИТ Г-6 -ФДГ, ГЕКСОКИНАЗЫ, ПИРУВАТКИНАЗЫ, ГЕКСОФОСФАТИЗОМЕРАЗА –нарушение выработки АТФ II. ПРИОБРЕТЕННЫЕ ОСТРЫЕ (МАРШЕВАЯ Hb –УРИЯ, ПОСТТРАНСФУЗИОННЫЕ, ТОКСИЧЕСКИЕ) ХРОНИЧЕСКИЕ (Б-НЬ МАРКИАФАВЫМИКЕЛЕ, ИММУННЫЕ ГА, СИМПТОМАТИЧЕСКИЕ ГА)
Классификация ГА I. ВРОЖДЕННЫЕ Ø ЭРИТЦИТОПАТИИ =мембранопатии Ø Ø (МИКРОСФЕРОЦИТОЗ-б-нь Минковского-Шоффара; СФЕРОЦИТОЗ; ОВАЛОЦИТОЗ; СТОМАТОЦИТОЗ) ГЕМОГЛОБИНОПАТИИ (ТАЛАССЕМИЯ, СЕРПОВИДНОКЛЕТОЧНАЯ АНЕМИЯ) ФЕРМЕНТОПАТИИ (ДЕФИЦИТ Г-6 -ФДГ, ГЕКСОКИНАЗЫ, ПИРУВАТКИНАЗЫ, ГЕКСОФОСФАТИЗОМЕРАЗА –нарушение выработки АТФ II. ПРИОБРЕТЕННЫЕ ОСТРЫЕ (МАРШЕВАЯ Hb –УРИЯ, ПОСТТРАНСФУЗИОННЫЕ, ТОКСИЧЕСКИЕ) ХРОНИЧЕСКИЕ (Б-НЬ МАРКИАФАВЫМИКЕЛЕ, ИММУННЫЕ ГА, СИМПТОМАТИЧЕСКИЕ ГА)
 Общие признаки гемолиза 1. Желтуха 2. Спленомегалия 3. Кризовое течение. 4. Снижение уровня гемоглобина 5. Ретикулоцитоз 6. Гипербилирубенемия (непрямая фракция) 7. Уробилинурия 8. Гиперплазия эритроидного ростка 9. Положительная реакция Кумбса в разв. >1: 4 10. Î ферритина
Общие признаки гемолиза 1. Желтуха 2. Спленомегалия 3. Кризовое течение. 4. Снижение уровня гемоглобина 5. Ретикулоцитоз 6. Гипербилирубенемия (непрямая фракция) 7. Уробилинурия 8. Гиперплазия эритроидного ростка 9. Положительная реакция Кумбса в разв. >1: 4 10. Î ферритина
 Кризы 2 типов - гемолитический и апластический (реже). Гемолитический-при стрессе, охлаждении, беременности. Желтуха, но желчных пигментов в моче нет. М. б. боли в животе, рвота, лихорадка. Апластический- при вирусных инфекциях. Аплазия костного мозга.
Кризы 2 типов - гемолитический и апластический (реже). Гемолитический-при стрессе, охлаждении, беременности. Желтуха, но желчных пигментов в моче нет. М. б. боли в животе, рвота, лихорадка. Апластический- при вирусных инфекциях. Аплазия костного мозга.
 Наследственная микросфероцитарная гемолитическая анемия (б-нь Минковского. Шоффара) Дефект белков мембраны эритроцитов, приобретающих сферическую форму с последующим их разрушением макрофагами селезенки. Широко распространена в Европе, в меньшей степени — на Африканском континенте, в Японии и других странах, нередко встречается в нашей стране. Она проявляется в любом возрасте, чаще в детском и подростковом, встречается у близких родственников больного. Существует бессимптомное носительство гена микросфероцитоза.
Наследственная микросфероцитарная гемолитическая анемия (б-нь Минковского. Шоффара) Дефект белков мембраны эритроцитов, приобретающих сферическую форму с последующим их разрушением макрофагами селезенки. Широко распространена в Европе, в меньшей степени — на Африканском континенте, в Японии и других странах, нередко встречается в нашей стране. Она проявляется в любом возрасте, чаще в детском и подростковом, встречается у близких родственников больного. Существует бессимптомное носительство гена микросфероцитоза.
 Этиология § наследуется по аутосомнодоминантному типу, встречается в основном гетерозиготная форма заболевания.
Этиология § наследуется по аутосомнодоминантному типу, встречается в основном гетерозиготная форма заболевания.
 Патогенез
Патогенез
 Клиническая картина. 1. Внешний вид – монголоидное лицо, «башенный» череп, микрофтальм, высокое небо и т. п. ; 2. Слабость, быстрая утомляемость, одышка при нагрузке, сердцебиение, головокружение. 3. Бледность кожи и слизистых, желтушность склер, ЖКБ-у 85%. М. б. трофические язвы голеней.
Клиническая картина. 1. Внешний вид – монголоидное лицо, «башенный» череп, микрофтальм, высокое небо и т. п. ; 2. Слабость, быстрая утомляемость, одышка при нагрузке, сердцебиение, головокружение. 3. Бледность кожи и слизистых, желтушность склер, ЖКБ-у 85%. М. б. трофические язвы голеней.

 Гематологически-умеренная анемия, Rtc>10%, сфероциты, средняя концентрация Hb повышена до 37 -39%. (особенно при инкубации при 37º С). Продолжительность жизни эритроцитов снижена. Терапия - Спленэктомия.
Гематологически-умеренная анемия, Rtc>10%, сфероциты, средняя концентрация Hb повышена до 37 -39%. (особенно при инкубации при 37º С). Продолжительность жизни эритроцитов снижена. Терапия - Спленэктомия.
 Дефицит Г-6 -ФД Наследование сцеплено с Х-хромосомой. Чаще проявляется у мужчин. Факторы риска: -инфекции и другие остро развивщиеся заболевания (н-р, диабетический кетоацидоз); -лекарственные препараты: СА, противомалярийные, нитрофураны, анальгетики, аспирин, противогельминтные препараты; -продукты питания (конские бобы, черника, голубика)
Дефицит Г-6 -ФД Наследование сцеплено с Х-хромосомой. Чаще проявляется у мужчин. Факторы риска: -инфекции и другие остро развивщиеся заболевания (н-р, диабетический кетоацидоз); -лекарственные препараты: СА, противомалярийные, нитрофураны, анальгетики, аспирин, противогельминтные препараты; -продукты питания (конские бобы, черника, голубика)
 Варианты ДГ-6 -ФДГ 4 класса (ВОЗ) § 1 -й класс — варианты с хронической гемолитической анемией. § 2 -й класс — варианты с уровнем активности фермента в эритроцитах 0— 10% от нормы, носительство которых обусловливает отсутствие гемолитической анемии вне обострения, а обострения связаны с приемом лекарств или употреблением в пищу конских бобов.
Варианты ДГ-6 -ФДГ 4 класса (ВОЗ) § 1 -й класс — варианты с хронической гемолитической анемией. § 2 -й класс — варианты с уровнем активности фермента в эритроцитах 0— 10% от нормы, носительство которых обусловливает отсутствие гемолитической анемии вне обострения, а обострения связаны с приемом лекарств или употреблением в пищу конских бобов.
 § 3 -й класс — варианты с уровнем активности фермента в эритроцитах 10— 60% от нормы, при которых могут быть легкие признаки гемолитической анемии, связанные с приемом лекарств. § 4 -й класс — варианты с нормальным или близким к норме уровнем активности фермента без каких-либо проявлений.
§ 3 -й класс — варианты с уровнем активности фермента в эритроцитах 10— 60% от нормы, при которых могут быть легкие признаки гемолитической анемии, связанные с приемом лекарств. § 4 -й класс — варианты с нормальным или близким к норме уровнем активности фермента без каких-либо проявлений.
 Клиника Темная моча Провоц. ф-р Лихорадка рвота понос гипотония Спленогепатомегалия Черная моча ОПН
Клиника Темная моча Провоц. ф-р Лихорадка рвота понос гипотония Спленогепатомегалия Черная моча ОПН
 Диагностика § Анемия; § Ретикулоцитоз; § Лейкоцитоз (иногда, особенно у детей, количество лейкоцитов может стать очень большим (100 х 109/л и выше). § Свободный Hb; § Гипербилирубинемия. § В моче также появляется гемоглобин.
Диагностика § Анемия; § Ретикулоцитоз; § Лейкоцитоз (иногда, особенно у детей, количество лейкоцитов может стать очень большим (100 х 109/л и выше). § Свободный Hb; § Гипербилирубинемия. § В моче также появляется гемоглобин.
 Лечение § необходимо лишь при выраженных признаках острого разрушения эритроцитов. При гемолитической анемии 1 -го класса иногда спленэктомия. § При нетяжелых гемолитических кризах с устранение причинного фактора.
Лечение § необходимо лишь при выраженных признаках острого разрушения эритроцитов. При гемолитической анемии 1 -го класса иногда спленэктомия. § При нетяжелых гемолитических кризах с устранение причинного фактора.
 Талассемия - гетерогенная группа гемоглобинопатий, в основе которых лежит снижение синтеза полипептидных цепей, входящих в структуру нормального гемоглобина А. Талассемия - это мишеневидно-клеточная анемия с нарушенным соотношением НЬА и Hb. F, при этом возможна частичная недостаточность определенной цепи или ее полное отсутствие при преобладании другой цепи.
Талассемия - гетерогенная группа гемоглобинопатий, в основе которых лежит снижение синтеза полипептидных цепей, входящих в структуру нормального гемоглобина А. Талассемия - это мишеневидно-клеточная анемия с нарушенным соотношением НЬА и Hb. F, при этом возможна частичная недостаточность определенной цепи или ее полное отсутствие при преобладании другой цепи.
 Патогенез § мутация в локусе ß-глобина на 11 -й паре хромосом нарушает синтез ß-глобиновой цепи. Вследствие неадекватного синтеза гемоглобина развивается гипохромная анемия. Преципитаты избыточного количества а-цепей удаляются из эритроцитов и эритрокариоцитов клетками ретикулогистиоцитарной системы; при этом клетки повреждаются и быстрее разрушаются.
Патогенез § мутация в локусе ß-глобина на 11 -й паре хромосом нарушает синтез ß-глобиновой цепи. Вследствие неадекватного синтеза гемоглобина развивается гипохромная анемия. Преципитаты избыточного количества а-цепей удаляются из эритроцитов и эритрокариоцитов клетками ретикулогистиоцитарной системы; при этом клетки повреждаются и быстрее разрушаются.
 § При ß-талассемии накапливается также Hb. F, обладающий большим сродством к кислороду; однако отдача его тканям затруднена, что приводит к их гипоксии. Неэффективный эритропоэз способствует расширению плацдарма кроветворения, что отражается на структуре скелета; вместе с тем деструкция эритрокариоцитов в костном мозге ведет к повышенному всасыванию железа и патологической перегрузке организма железом.
§ При ß-талассемии накапливается также Hb. F, обладающий большим сродством к кислороду; однако отдача его тканям затруднена, что приводит к их гипоксии. Неэффективный эритропоэз способствует расширению плацдарма кроветворения, что отражается на структуре скелета; вместе с тем деструкция эритрокариоцитов в костном мозге ведет к повышенному всасыванию железа и патологической перегрузке организма железом.
 α, β, γ, δ-талассемия Клиника – большая голова, запавший нос, монголоидные черты лица, желтушность, бледность, гепатоспленомегалия, хронические язвы голеней, отеки до анасарки. Часто инфекции, которые являются причинами смерти. Rg-утолщение губчатого слоя свода черепа. Гематологическая картина- гипохромная анемия, при повышенном содержании Fe, микроцитоз, СОЭ. .
α, β, γ, δ-талассемия Клиника – большая голова, запавший нос, монголоидные черты лица, желтушность, бледность, гепатоспленомегалия, хронические язвы голеней, отеки до анасарки. Часто инфекции, которые являются причинами смерти. Rg-утолщение губчатого слоя свода черепа. Гематологическая картина- гипохромная анемия, при повышенном содержании Fe, микроцитоз, СОЭ. .
 Мазок крови при талассемии
Мазок крови при талассемии
 Большая талассемия: внешний вид. Гепатоспленомегалия и низкорослость.
Большая талассемия: внешний вид. Гепатоспленомегалия и низкорослость.
 Большая талассемия: спленомегалия
Большая талассемия: спленомегалия
 Серповидно-клеточная анемия Клиника- башенный череп, инфантилизм, тромбозы сосудов ведут к поражению суставов, м. б. , асептический некроз головок костей, часты сосудистые нарушения зрения, повторные инфаркты селезенки. Гематологическая картина - нормохромная анемия, эритроциты серповидной формы, ретикулоцитоз, СОЭ в норме.
Серповидно-клеточная анемия Клиника- башенный череп, инфантилизм, тромбозы сосудов ведут к поражению суставов, м. б. , асептический некроз головок костей, часты сосудистые нарушения зрения, повторные инфаркты селезенки. Гематологическая картина - нормохромная анемия, эритроциты серповидной формы, ретикулоцитоз, СОЭ в норме.
Мазок крови при серповидноклеточной анемии
Мазок крови при серповидноклеточной анемии
 Приобретенные гемолитические анемии Гемолитическая болезнь плода - антигенные различия Er матери и плода, а/т матери проникают через плаценту и разрушают Er плода (антигены системы резус D, реже а/г С, Е и групповых а/г А и В. Клиника- гепатоспленомегалия, желтуха в 1 -е сутки, кардиомегалия и НК, увеличение непрямого билирубина поражение н. с. (судороги, гипертонус, нистагм). Гематологически - анемия, ретикулоцитоз, лейкоцитоз со сдвигом влево. Лечение- симптоматическое.
Приобретенные гемолитические анемии Гемолитическая болезнь плода - антигенные различия Er матери и плода, а/т матери проникают через плаценту и разрушают Er плода (антигены системы резус D, реже а/г С, Е и групповых а/г А и В. Клиника- гепатоспленомегалия, желтуха в 1 -е сутки, кардиомегалия и НК, увеличение непрямого билирубина поражение н. с. (судороги, гипертонус, нистагм). Гематологически - анемия, ретикулоцитоз, лейкоцитоз со сдвигом влево. Лечение- симптоматическое.
 Аутоиммунные гемолитические анемии § Симптоматические – гемобластозы, СКВ, РА, Ne. O, иммунодефицитные состояния. § Идиопатические: -с неполными тепловыми агглютининами; -с тепловыми гемолизинами; -с полными холодовыми агглютининами; -с двухфазными гемолизинами.
Аутоиммунные гемолитические анемии § Симптоматические – гемобластозы, СКВ, РА, Ne. O, иммунодефицитные состояния. § Идиопатические: -с неполными тепловыми агглютининами; -с тепловыми гемолизинами; -с полными холодовыми агглютининами; -с двухфазными гемолизинами.
 Патогенез АИГА § Неполные тепловые агглютинины фиксируются на эритроцитах, не вызывая их агглютинации, изменяя проницаемость мембраны эритроцитов для ионов натрия, развивается сфероцитоз, который приводит к элиминации эритроцитов в селезенке – гемолиз внутриклеточный.
Патогенез АИГА § Неполные тепловые агглютинины фиксируются на эритроцитах, не вызывая их агглютинации, изменяя проницаемость мембраны эритроцитов для ионов натрия, развивается сфероцитоз, который приводит к элиминации эритроцитов в селезенке – гемолиз внутриклеточный.
 § Тепловые гемолизины, холодовые агглютинины и двухфазные гемолизины вызывают разрушение эритроцитов в сосудистом русле, тем самым приводят к развитию сосудистого гемолиза.
§ Тепловые гемолизины, холодовые агглютинины и двухфазные гемолизины вызывают разрушение эритроцитов в сосудистом русле, тем самым приводят к развитию сосудистого гемолиза.
 ГА с тепловыми гемолизинами Клиника- постепенное начало, умеренная желтуха. Селезенка и печень увеличена менее чем у ½. Характерно – черная моча. М. б. тромбозы вен боли в животе. Анализ крови - анемия, ретикулоцитоз, лейкоцитоз со сдвигом влево. Анализ мочи – протеинурия. Положительная сахарозная собственными эритроцитами. проба с
ГА с тепловыми гемолизинами Клиника- постепенное начало, умеренная желтуха. Селезенка и печень увеличена менее чем у ½. Характерно – черная моча. М. б. тромбозы вен боли в животе. Анализ крови - анемия, ретикулоцитоз, лейкоцитоз со сдвигом влево. Анализ мочи – протеинурия. Положительная сахарозная собственными эритроцитами. проба с
 § Аутоиммунная гемолитическая анемия: желтушность склер.
§ Аутоиммунная гемолитическая анемия: желтушность склер.

 ГА с неполными тепловыми агглютининами Клиника- м. б. , внезапное начало-лихорадка, боли в сердце, пояснице, одышка, желтуха. М. б. , постепенное начало с артралгии, нарастающая анемизация, гепатои спленомегалия. М. б. , тромбозы периферических вен, мезентериальных сосудов боли в животе Анализ крови- анемия, ретикулоцитоз, лейкоцитоз со сдвигом влево, анизоцитоз и полихромазия, СОЭ. Биохимия- непрямой билирубин, уробилин, стеркобилин. М. б. , положительная реакция Вассермана. СОЭ. Положительная прямая проба Кумбса (неполные а/т на поверхности эритроцитов)
ГА с неполными тепловыми агглютининами Клиника- м. б. , внезапное начало-лихорадка, боли в сердце, пояснице, одышка, желтуха. М. б. , постепенное начало с артралгии, нарастающая анемизация, гепатои спленомегалия. М. б. , тромбозы периферических вен, мезентериальных сосудов боли в животе Анализ крови- анемия, ретикулоцитоз, лейкоцитоз со сдвигом влево, анизоцитоз и полихромазия, СОЭ. Биохимия- непрямой билирубин, уробилин, стеркобилин. М. б. , положительная реакция Вассермана. СОЭ. Положительная прямая проба Кумбса (неполные а/т на поверхности эритроцитов)
 ГА с полными холодовыми агглютининами. Клиника-начало постепенное, слабость, быстрая утомляемость, непереносимость холода, часто синдром Рейно, при длительном воздействии холода м. б. гангрена пальцев. Иногда гепато- и спленомегалия. Биохимия - обнаруживается М-градиент (содержит холодовые агглютинины). Часто аутоагглютинация в мазке крови и пробирке при комнатной tº.
ГА с полными холодовыми агглютининами. Клиника-начало постепенное, слабость, быстрая утомляемость, непереносимость холода, часто синдром Рейно, при длительном воздействии холода м. б. гангрена пальцев. Иногда гепато- и спленомегалия. Биохимия - обнаруживается М-градиент (содержит холодовые агглютинины). Часто аутоагглютинация в мазке крови и пробирке при комнатной tº.

 Лечение ГА § Устранение причины острого гемолиза; § При кризах – ГКС-терапия; § Спленэктомия (при аутоиммунных ГА и сфероцитозе) § Эксиджад (ликвидация вторичного гемосидероза) § Эритропоэтин ( при гемоглобинопатиях) § Переливания крови (Î Î Î очень осторожно, т. к. ведет к гемосидерозу, только при тяжелых гемолитических кризах)
Лечение ГА § Устранение причины острого гемолиза; § При кризах – ГКС-терапия; § Спленэктомия (при аутоиммунных ГА и сфероцитозе) § Эксиджад (ликвидация вторичного гемосидероза) § Эритропоэтин ( при гемоглобинопатиях) § Переливания крови (Î Î Î очень осторожно, т. к. ведет к гемосидерозу, только при тяжелых гемолитических кризах)
 Апластическая анемия- это функциональная недостаточность костного мозга, в результате чего нарушается пролиферация и дифференциация клеток последнего.
Апластическая анемия- это функциональная недостаточность костного мозга, в результате чего нарушается пролиферация и дифференциация клеток последнего.
 Этиология. § Ионизирующая радиация; § Химические вещества; § Цитотоксические препараты; § Вирусные инфекции (вирусный гепатит); § Наследственные факторы (анемия Фанкони, син-м Даймонда-Блекфана, наслед. дефицит гормонов поджелудочной железы); § Лекарственные препараты (сульфаниламиды; левомицетин; аминазин и др).
Этиология. § Ионизирующая радиация; § Химические вещества; § Цитотоксические препараты; § Вирусные инфекции (вирусный гепатит); § Наследственные факторы (анемия Фанкони, син-м Даймонда-Блекфана, наслед. дефицит гормонов поджелудочной железы); § Лекарственные препараты (сульфаниламиды; левомицетин; аминазин и др).
 Классификация 1. Наследственные (врожденные); 2. Приобретенные: - первичные (идиопатические); - вторичные.
Классификация 1. Наследственные (врожденные); 2. Приобретенные: - первичные (идиопатические); - вторичные.
 Клиника 1. Анемический синдром -слабость, одышка, сердцебиение при физической нагрузке. 2. Геморрагический синдром – кровотечения из носа, десен, маточные и желудочные, на глазном дне, петехиально-пятнистый тип кровоизлияний на коже.
Клиника 1. Анемический синдром -слабость, одышка, сердцебиение при физической нагрузке. 2. Геморрагический синдром – кровотечения из носа, десен, маточные и желудочные, на глазном дне, петехиально-пятнистый тип кровоизлияний на коже.
 3. С-м инфекционных осложнений – пневмонии, ангины, отиты, пиелиты, абсцессы); 4. Гематологический синдром – характерные изменения в крови.
3. С-м инфекционных осложнений – пневмонии, ангины, отиты, пиелиты, абсцессы); 4. Гематологический синдром – характерные изменения в крови.
 Течение: По тяжести течения: § Нетяжелая (L<1, 5 x 10. 9/л) § Тяжелая (L<0, 5 x 10. 9/л; Trb <20 x 10. 9/л; Ret<1%) § Очень тяжелая (L<0, 2 x 10. 9/л; Trb <5 x 10. 9/л)
Течение: По тяжести течения: § Нетяжелая (L<1, 5 x 10. 9/л) § Тяжелая (L<0, 5 x 10. 9/л; Trb <20 x 10. 9/л; Ret<1%) § Очень тяжелая (L<0, 2 x 10. 9/л; Trb <5 x 10. 9/л)
 Диагностика: § ОАК – анемия разной степени выраженности; § Панцитопения (лейкопения, нейтропения с абсолютной лимфопенией; тромбоцитопения); § Анизо-пойкилоцитоз; § Нормо-или-макроцитоз; § Ускоренная СОЭ.
Диагностика: § ОАК – анемия разной степени выраженности; § Панцитопения (лейкопения, нейтропения с абсолютной лимфопенией; тромбоцитопения); § Анизо-пойкилоцитоз; § Нормо-или-макроцитоз; § Ускоренная СОЭ.
 Диагностика: § Миелограмма - опустошенный костный мозг, местами имеются небольшие очаги кроветворения. § Гистологически- запустевание костного мозга – соотношение кроветворных клеток и жира 1: 3 -4 (при норме 1: 1). § Иммунные нарушения- аутоантитела к клеткам костного мозга; снижение CD 41 и CD 8+ лимфоцитов.
Диагностика: § Миелограмма - опустошенный костный мозг, местами имеются небольшие очаги кроветворения. § Гистологически- запустевание костного мозга – соотношение кроветворных клеток и жира 1: 3 -4 (при норме 1: 1). § Иммунные нарушения- аутоантитела к клеткам костного мозга; снижение CD 41 и CD 8+ лимфоцитов.
 Апластическая анемия: кровоизлияния в слизистые.
Апластическая анемия: кровоизлияния в слизистые.
 ЛЕЧЕНИЕ -Антилимфоцитарный глобулин (АТГАМ), -циклоспорин, ГК, -эритропоэтин (эпрекс, рекормон, эпомакс) , -КСФ (нейпоген, граноцит, лейкомакс) - Трансплантация костного мозга.
ЛЕЧЕНИЕ -Антилимфоцитарный глобулин (АТГАМ), -циклоспорин, ГК, -эритропоэтин (эпрекс, рекормон, эпомакс) , -КСФ (нейпоген, граноцит, лейкомакс) - Трансплантация костного мозга.
 БЛАГОДАРЮ ЗА ВНИМАНИЕ
БЛАГОДАРЮ ЗА ВНИМАНИЕ


